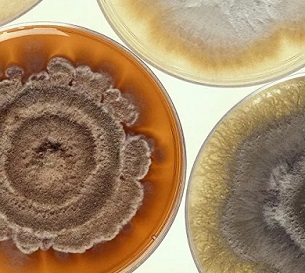
Scientists Find Bacteria so Alien to Human Immune System It Can’t Detect It. Credit - CC0

A study led by Boston University has discovered deep-sea bacteria so foreign to the human immune system that immune cells do not register it...The researchers harvested the new types of microbial organisms 4,000 meters below the surface in one of the largest and deepest marine protected areas in the world, located in the Phoenix Islands Protected Area in Kiribati in the central Pacific Ocean.









